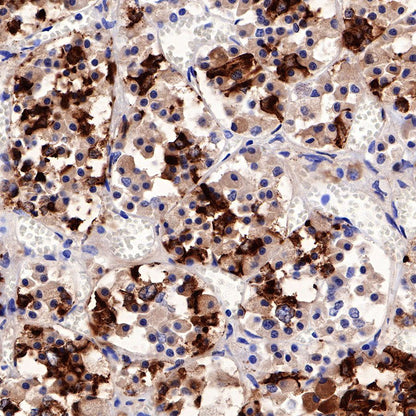

Product Details
Product Details
Product Specification
| Host | Rabbit |
| Antigen | Prolactin/PRL |
| Synonyms | Prolactin, PRL |
| Immunogen | Recombinant Protein |
| Accession | P01236 |
| Clone Number | SDT-235-13 |
| Antibody Type | Rabbit mAb |
| Application | IHC-P |
| Reactivity | Hu |
| Purification | Protein A |
| Concentration | 0.25 mg/ml |
| Physical Appearance | Liquid |
| Storage Buffer | PBS, 40% Glycerol, 0.05% BSA, 0.03% Proclin 300 |
| Stability & Storage | 12 months from date of receipt / reconstitution, -20 °C as supplied |
Dilution
| application | dilution | species |
| IHC-P | 1:1000 | null |
Background
Prolactin is a hormone that is mainly synthesized and secreted by lactotroph cells in the anterior pituitary gland. Prolactin signalling occurs via a unique transmembrane prolactin receptor (PRL-R). The structure of the PRL-R has now been elucidated and is similar to that of many biologically fundamental receptors of the class 1 haematopoietic cytokine receptor family such as the growth hormone receptor. The PRL-R is expressed in a wide array of tissues, and a growing number of biological processes continue to be attributed to prolactin [PMID: 30899100].
Picture
Picture
Immunohistochemistry

IHC shows positive staining in paraffin-embedded human pituitary. Anti-Prolactin/PRL antibody was used at 1/1000 dilution, followed by a HRP Polymer for Mouse & Rabbit IgG (ready to use). Counterstained with hematoxylin. Heat mediated antigen retrieval with Tris/EDTA buffer pH9.0 was performed before commencing with IHC staining protocol.

Negative control: IHC shows negative staining in paraffin-embedded human cerebral cortex. Anti-Prolactin/PRL antibody was used at 1/1000 dilution, followed by a HRP Polymer for Mouse & Rabbit IgG (ready to use). Counterstained with hematoxylin. Heat mediated antigen retrieval with Tris/EDTA buffer pH9.0 was performed before commencing with IHC staining protocol.